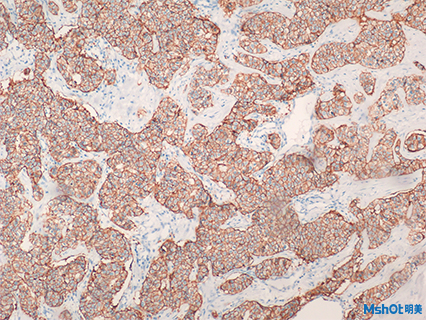
病理圖

由SARS-CoV-2引起的冠狀病毒疾病2019 (COVID-19)已迅速演變?yōu)橐环N廣泛的流行病。 雖然其主要表現(xiàn)在呼吸道,但器官受累的一般程度以及肺部的微觀變化仍然不夠明顯。 尸檢對于闡明COVID-19相關(guān)器官的改變是必不可少的。
來自瑞士巴塞爾大學(xué)醫(yī)學(xué)院醫(yī)學(xué)遺傳與病理研究所的Thomas Menter教授(Orcid ID: 0000-0002-0847-6156)和瑞士巴塞蘭州立病理學(xué)研究所的Alexandar Tzankov教授 (Orcid ID: 0000-0002-1100-3819)及其團(tuán)隊(duì),采用了一種體內(nèi)技術(shù),對在兩家住院的21位COVID-19患者的尸體進(jìn)行了解剖,尸檢結(jié)果表明高血壓、年老、肥胖、患有心血管并發(fā)癥的男性個體以及血型為A的男性可能對COVID-19的耐受性閾值較低。為這些患者的高死亡率提供了一種病理生理解釋。
A:COVID-19肺的典型表現(xiàn);明顯增厚的肺泡間隔和充血性間質(zhì)插入,插入:詳細(xì)的視圖突出間質(zhì)充血;
B:廣泛的支氣管肺炎浸潤在一例合并化膿性肺炎的COVID-19例患者中。

A:滲出性彌漫性肺泡損傷(DAD)表現(xiàn)為離散的透明膜和明顯的毛細(xì)血管充血 (H&E, 200x), 插入:顯示透明膜范圍的纖維蛋白免疫組化(IHC) (100x);
B: 肺細(xì)胞II起源的合胞細(xì)胞(H&E, 400x), 插入: TTF1的免疫組化 (400x);
C: 無DAD的大面積毛細(xì)血管充血(H&E, 200x);
D: 肺泡毛細(xì)血管微血栓(纖維蛋白IHC, 360x)。

A:腎臟顯示急性腎小管損傷,但沒有炎癥浸潤增加的證據(jù)(PAS,100x);
B:腎臟顯示彌散性血管內(nèi)凝血(PAS,400x);
C:花性脾炎表現(xiàn)為脾周和邊緣區(qū)中性粒細(xì)胞增多(PAS,200x);
D:淋巴結(jié)顯示葉間區(qū)漿細(xì)胞增多和充血(H&E, 160x); 插入: MUM1免疫組化 (200x)。

A,B:足細(xì)胞細(xì)胞質(zhì),其足突位于含有線粒體(左上角)和多個囊泡的腎小球基底膜上,其中兩個含有幾個大小在70至110nm之間的小病毒樣顆粒(箭頭)。在較高的放大率下,囊泡含有雙膜,病毒樣顆粒呈電子致密顆粒環(huán)和粗糙的外部輪廓 (電鏡,原始放大倍數(shù)36,000x(A),71,000x(B))。
C: 一個活化的腎小球內(nèi)皮細(xì)胞,一個靠近管腔邊緣的有病毒樣顆粒(箭頭和插入)的囊泡,與紅細(xì)胞相鄰(左上方的電子致密結(jié)構(gòu));電子顯微鏡,原始放大14,000x,插入89,000x)。
D:淋巴結(jié)顯示葉間區(qū)漿細(xì)胞增多和充血(H&E, 160x); 插入: MUM1免疫組化 (200x)。
研究結(jié)果表明,這些COVID-19患者死亡的主要原因是呼吸衰竭,滲出性彌漫性肺泡損傷,大量毛細(xì)血管充血,常伴有微血栓,盡管采取了抗凝。10例表現(xiàn)為支氣管肺炎。進(jìn)一步的發(fā)現(xiàn)包括肺栓塞(n=4)、肺泡出血(n=3)和血管炎(n=1)。其他器官系統(tǒng)的病理主要?dú)w因于休克;3名患者表現(xiàn)出全身血栓性微血管病變的跡象。尸檢診斷為老年心臟淀粉樣變性6例。大多數(shù)患者患有一種或多種并發(fā)癥(高血壓、肥胖、心血管疾病、糖尿?。?。此外,男性和血型為A個體有總體優(yōu)勢。
論文原文可通過以下鏈接查看! https://onlinelibrary.wiley.com/doi/abs/10.1111/his.14134
明美自主研發(fā)大體成像儀ME20-Z/ME30-Z及數(shù)碼成像系統(tǒng)MS60/MSX1/MSX2 具有好的數(shù)據(jù)處理、高還原性。能還原樣品的精細(xì)結(jié)構(gòu)和真實(shí)色彩。是病理學(xué)診斷的理想工具。

明美是一家專注顯微成像產(chǎn)品研發(fā)與銷售的高新技術(shù)企業(yè),是中國儀器儀表行業(yè)協(xié)會光學(xué)分會理事單位,醫(yī)療器械顯微鏡生產(chǎn)及經(jīng)營廠家。
公司一直堅(jiān)持誠信經(jīng)營,用心服務(wù),使明美M-Shot品牌在國內(nèi)外高校、研究所、醫(yī)療及企業(yè)客戶中形成良好的口碑,公司持續(xù)穩(wěn)步發(fā)展。
您若對明美大體成像及數(shù)碼成像系統(tǒng)有興趣或存在疑惑,明美光電歡迎您咨詢,期待與您相約!
相關(guān)文章閱讀推薦: